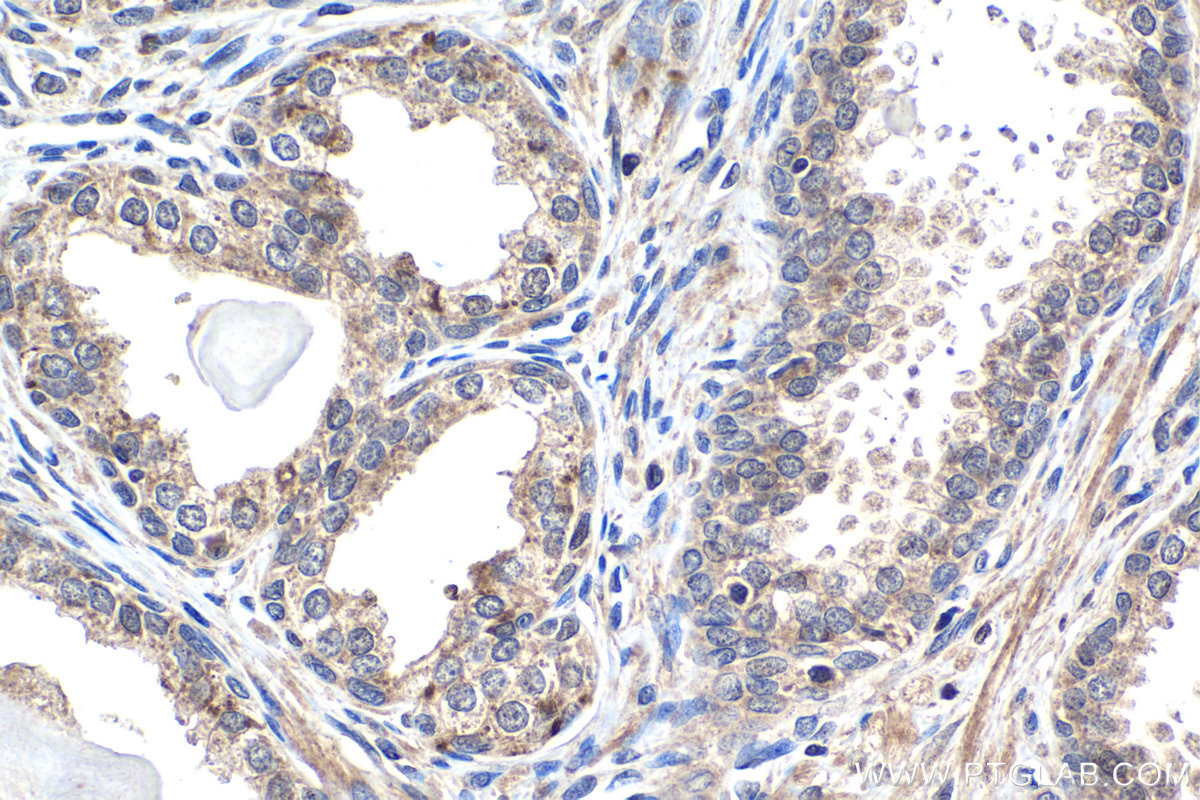
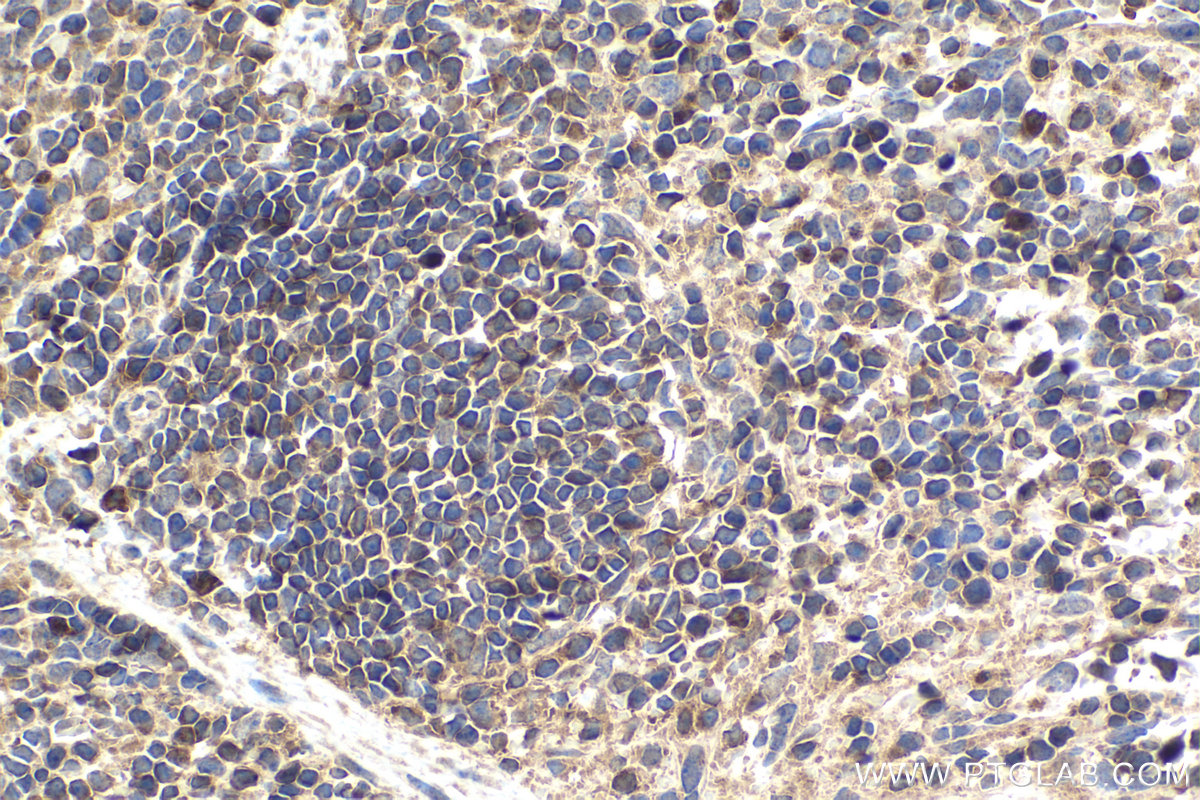

IHCeasy® PRKCB Ready-To-Use IHC Kit
PRKCB Ready-to-use reagent kit for IHC.
Reactivity
Human, Mouse, Rat
Sample Type
FFPE tissue
Cat no : KHC1510
Synonyms
pan-PKC, PKC B, PKC beta, PKCB, PRKCB, PRKCB1, PRKCB2, Protein kinase C beta type, protein kinase C, beta
Validation Data Gallery
Product Information
KHC1510 is a ready-to-use IHC kit for staining of PRKCB. The kit provides all reagents, from antigen retrieval to cover slip mounting, that require little to no diluting or handling prior to use. Simply apply the reagents to your sample slide according to the protocol and you're steps away from obtaining high-quality IHC data.
| Product name | IHCeasy PRKCB Ready-To-Use IHC Kit |
| Sample type | FFPE tissue |
| Assay type | Immunohistochemistry |
| Primary antibody type | Rabbit Polyclonal |
| Secondary antibody type | Polymer-HRP-Goat anti-Rabbit |
| Reactivity | Human, Mouse, Rat |
Kit components
| Component | Size | Concentration |
|---|---|---|
| Antigen Retrieval Buffer | 100 mL | 50× |
| Washing Buffer | 100 mL ×2 | 20× |
| Blocking Buffer | 5 mL | RTU |
| Primary Antibody | 5 mL | RTU |
| Secondary Antibody | 5 mL | RTU |
| Chromogen Component A | 0.2 mL | RTU |
| Chromogen Component B | 4 mL | RTU |
| Signal Enhancer | 5 mL | RTU |
| Counter Staining Reagent | 5 mL | RTU |
| Mounting Media | 5 mL | RTU |
| Datasheet | 1 Copy | |
| Manual | 1 Copy |
Background Information
Protein kinase C (PKC) is a family of serine- and threonine-specific protein kinases that can be activated by calcium and second messenger diacylglycerol. Protein kinase Cs (PKCs) are signaling molecules that play key roles in many cellular processes, including secretion, gene expression, proliferation, and muscle contraction. The PKC family is broadly divided into three subgroups: classical, novel, and atypical PKCs. These subgroups differ in both protein sequences and mechanistic requirements for catalytic activity. PKC beta is one of the PKC family members. PKC beta has been reported to be involved in many different cellular functions, such as B cell activation, apoptosis induction, endothelial cell proliferation, and intestinal sugar absorption. Studies in mice also suggest that this kinase may also regulate neuronal functions and correlate fear-induced conflict behavior after stress. The primary antibody in this kit can recognize PKC beta, PKC alpha, PKC gamma, PKC epsilon and PKC delta.
Properties
| Storage Instructions | All the reagents are stored at 2-8°C. The kit is stable for 6 months from the date of receipt. |
| Synonyms | pan-PKC, PKC B, PKC beta, PKCB, PRKCB, PRKCB1, PRKCB2, Protein kinase C beta type, protein kinase C, beta |